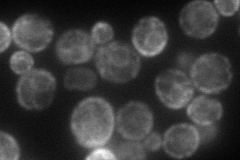
YMR134W
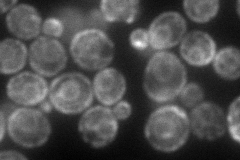
YMR134W
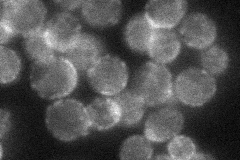
YMR134W
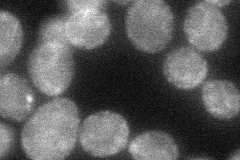
YMR134W
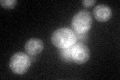
YMR134W
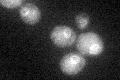
YMR134W

View description
Protein of unknown function that may be involved in iron metabolism; mutant bm-8 has a growth defect on iron-limited medium that is complemented by overexpression of Yfh1p; shows localization to the ER; highly conserved in ascomycetes
Localization:
Intensity:
Fold change:
Significance:
-
C’ GFP library in SD

ER43.48 -
N' NOP1pr-GFP in SD
ER98.6527 -
N' TEF2pr-mCherry in SD
ER,punctate105.297 -
N' NATIVEpr-GFP in SD
cell periphery,punctate40.6686 -
N' TEF2pr-VC and Cyto-VN in SD
punctate,bud neck43.4987 -
C’ GFP library in SD+DTT
ERN/AN/ANo -
C’ GFP library in SD+H2O2

ERN/AN/ANo -
C’ GFP library in Starvation Media
ERN/AN/AYes -
C’ GFP library on the background of Pup2-DaMP

ER -
C’ GFP library on the background of CCT mutant

ERN/AN/ANo
